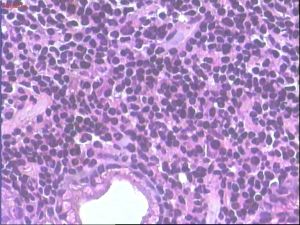
胃真菌病

胃真菌病胃真菌的存在極為廣泛。空氣水及食物中常有無數真菌,人類的口腔胃及腸道中也常有其蹤跡。平時僅為一種無害的寄生但在胃黏膜局部血循環障礙或免疫力減退時,可引起胃炎或潰瘍,甚至有穿孔及竇道形成。
發病機制
能引起胃真菌病的主要菌種是白色念珠菌(monilia albicans)和麴黴菌(aspergillus)而放線菌則較為少見。據Bearse的意見,胃黏膜的局部血循環障礙或免疫力的減退可能為真菌病的發生基礎。
初時常在胃黏膜上形成一層白喉樣的假膜以後再發展為潰瘍有時可發生黏膜下層血管的栓塞。潰瘍或為單數或為多數,有時很小,有時可能累及整個胃壁但一般不致形成穿孔。病灶上的壞死組織中常見有真菌存在,如屬放線菌感染則可見有硫磺顆粒。
臨床表現
胃真菌病臨床表現無特異性,在排除胃炎、胃潰瘍或癌腫後應考慮本病。活組織病理檢查可確診。鑑別診斷本病需與胃炎胃潰瘍和胃癌相鑑別。
臨床表現無特異性,可以似胃炎、胃潰瘍或癌腫而難於區分。X線檢查也不能對診斷有何幫助。雖然在嘔吐物及胃內容物中常能發現大量真菌,但因胃真菌病是如此少見,而胃內容物中可能發現真菌機會甚多,故單純發現真菌並不能認為是胃真菌病。文獻上所有已經報導的胃真菌病均未能有正確的臨床診斷,而最後的確診只能有賴於手術或活組織檢查。
診斷
臨床表現無特異性,在排除胃炎、胃潰瘍或癌腫後應考慮該病。活組織病理檢查可確診。
鑑別診斷
該病需與胃炎胃潰瘍和胃癌相鑑別。
實驗室檢查:
活組織病理檢查是確診本病的依據。切片可見假膜存在,鏡下可發現菌絲。
治療
胃真菌病手術前的正確診斷實屬困難,則非手術療法亦難確定其療效。Bearse認為:因碘化物對胃真菌病有效故對可疑的胃真菌病患者亦可試服大劑量的碘化物。在當前抗真菌藥物已經大大發展的情況下,胃真菌病的治療已完全改觀。因真菌病而致出血或穿孔者,應立即手術治療。
治療原則:套用抗生素及對症治療。
(一)少食多餐,定時定量,進柔軟易消化無刺激食物。去除病灶、戒斷菸酒、濃茶,慎用刺激胃的藥物。
(二)藥物治療
1、抗生素如黃連素0.2g,鏈黴素0.3g,慶大黴素8萬u,2-3次/日, 餐前服用,7-14天為一療程。麗珠得樂一包2次/日,餐前服用,2個月一療程。
2、制酸劑適用於胃酸正常或偏高的病人,如胃舒平,氫氧化鋁,組織胺H2受體拮抗劑(西米替丁、雷尼替丁、法莫替丁)、硫糖鋁等。
3、洛賽克20mg一次,早餐前服用,適用於萎縮性胃炎A型病人。
4、胃復安5-10mg3-4次/日,餐前、睡前服用。
5、胃腸動力藥嗎叮啉,適用於腹脹、食物及膽汁反流病人。
6、助消化劑適於低胃酸、無胃酸或服制酸劑無效的病人,給胃蛋白酶、1%稀鹽酸,餐後服用。
7、強的松適用於慢性萎縮性胃炎A型病人。5mg,每日一次,口服,一個月為一療程。
8、合併貧血的胃炎應糾正貧血。
謹防復發
飲食注意深秋初冬,一些原來有胃真菌病的人飲食起居稍不注意,就會舊疾復發。
冬季容易發生胃真菌病的原因?中國醫學認為,這是寒邪侵入腸胃所致,因為“寒性凝滯”,可致氣滯血瘀。現代醫學研究證實,冬天氣溫較低,當人體受到冷的刺激以後,體內會產生一系列的生理變化,使得甲狀腺和腎上腺機能亢進,交感神經興奮,致使甲狀腺素、腎上腺皮質激素和去甲腎上腺素等分泌增多,體內新陳代謝旺盛,產熱量增加;另一方面,又促使皮膚血管收縮,減少散熱,以幫助人體禦寒。但這些激素分泌增多的同時,對潰瘍等胃部疾患卻大為不利。如腎上腺皮質激素分泌增多,可促使胃液過量分泌,過多的酸性胃液則會刺激胃黏膜的潰瘍創面;去甲腎上腺素分泌增多,又可使胃黏膜的血管收縮,血液供應減少,使胃的功能減弱;而甲狀腺素的分泌增高,則可使基礎代謝旺盛,人體攝食量增加,又可加重胃的負擔。這一系列不利的變化,構成了胃真菌病發生或復發的重要隱患,因而冬天胃真菌病的發生率增多。
冬季預防胃真菌病發作的方法:首先,保持精神愉快,情緒穩定,避免緊張和焦慮等不良因素的刺激;合理安排工作和休息,注意勞逸結合,保證充足的睡眠,防止過度疲勞。其次,積極參加適度的體育鍛鍊,以改善胃腸道的血液循環,增強機體抗寒能力。再者,注意收聽氣象台的天氣預報,隨著氣候的冷暖變化及時增減衣服,防止腹部受涼,對防止胃疾復發也很重要。另外,有胃真菌病病史者,在飲食上應吃易於消化的熱飯菜,禁吃生冷辛辣食物,並戒除菸酒,進食時要細嚼慢咽,以利於消化吸收,減輕胃腸負擔。
注意事項
胃真菌病胃真菌病飲食:要注意以下11條原則:
1、少吃油炸食物:因為這類食物不容易消化,會加重消化道負擔,多吃會引起消化不良,還會使血脂增高,對健康不利。
2、少吃醃製食物:這些食物中含有較多的鹽分及某些可致癌物,不宜多吃。
3、少吃生冷食物刺激性食物:生冷和刺激性強的食物對消化道黏膜具有較強的刺激作用,容易引起腹瀉或消化道炎症。
4、規律飲食:研究表明,有規律地進餐,定時定量,可形成條件反射,有助於消化腺的分泌,更利於消化。
5、定時定量:要做到每餐食量適度,每日3餐定時,到了規定時間,不管肚子餓不餓,都應主動進食,避免過飢或過飽。
6、溫度適宜:飲食的溫度應以“不燙不涼”為度。
7、細嚼慢咽:以減輕胃腸負擔。對食物充分咀嚼次數愈多,隨之分泌的唾液也愈多,對胃黏膜有保護作用。
8、飲水擇時:最佳的飲水時間是晨起空腹時及每次進餐前1小時,餐後立即飲水會稀釋胃液,用湯泡飯也會影響食物的消化。
9.注意防寒:胃部受涼後會使胃的功能受損,故要注意胃部保暖不要受寒。
10、避免刺激:不吸菸,因為吸菸使胃部血管收縮,影響胃壁細胞的血液供應,使胃黏膜抵抗力降低而誘發胃真菌病。應少飲酒,少吃辣椒、胡椒等辛辣食物。
11、補充維生素C:維生素C對胃有保護作用,胃液中保持正常的維生素C的含量,能有效發揮胃的功能,保護胃部和增強胃的抗病能力。因此,要多吃富含維生素C的蔬菜和水果。